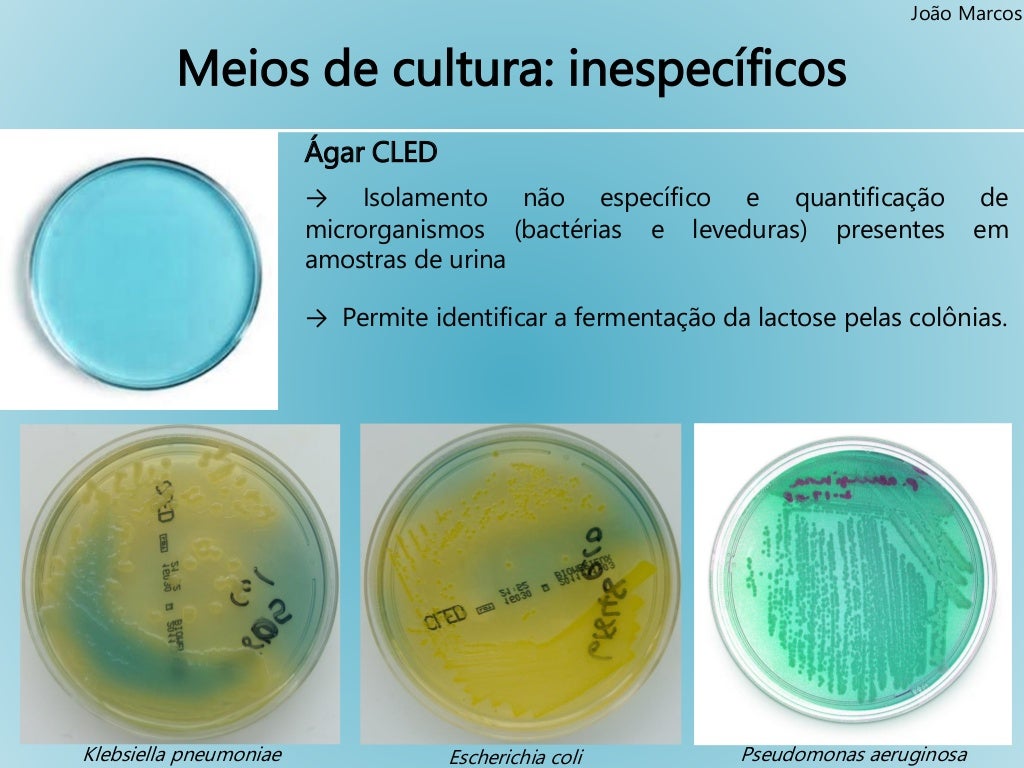
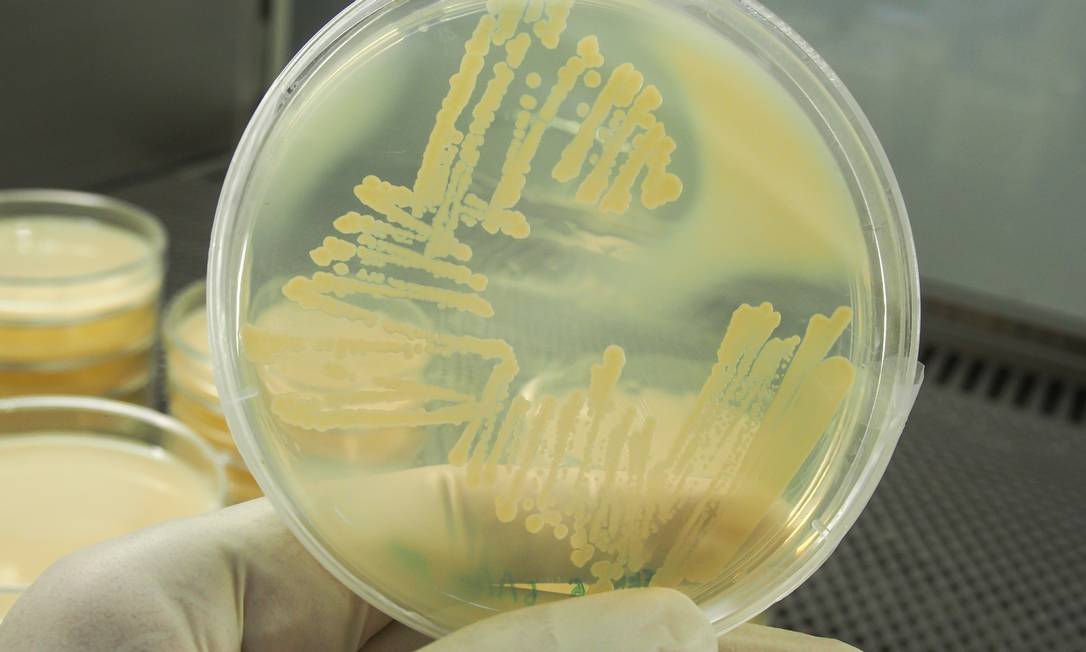
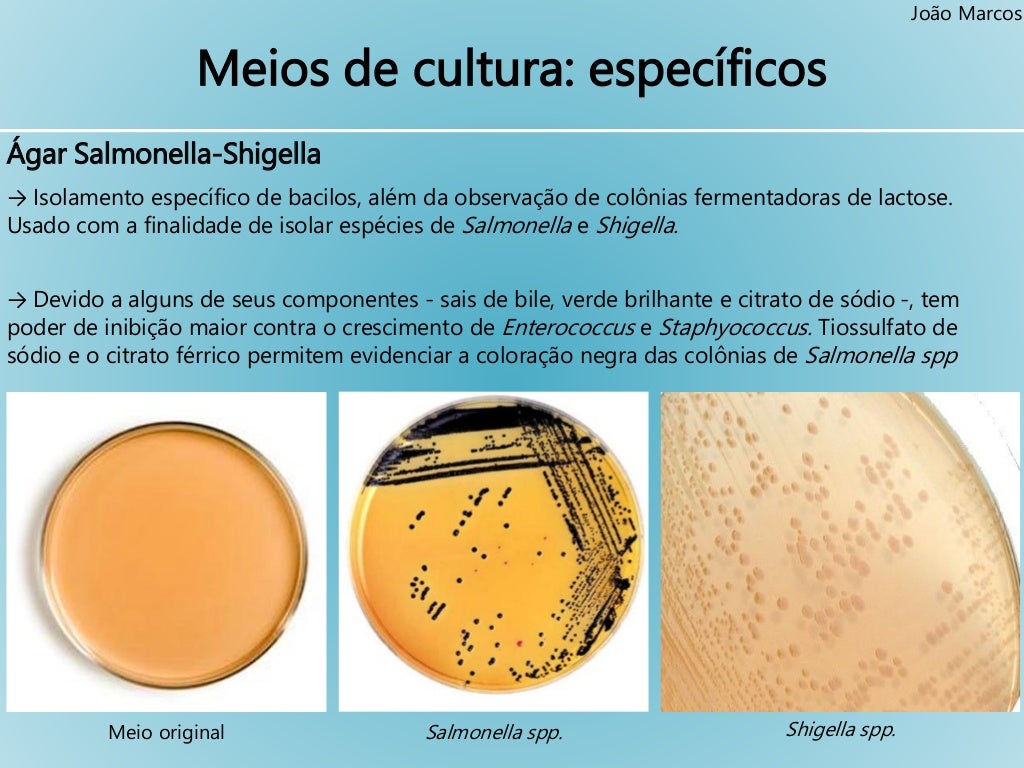
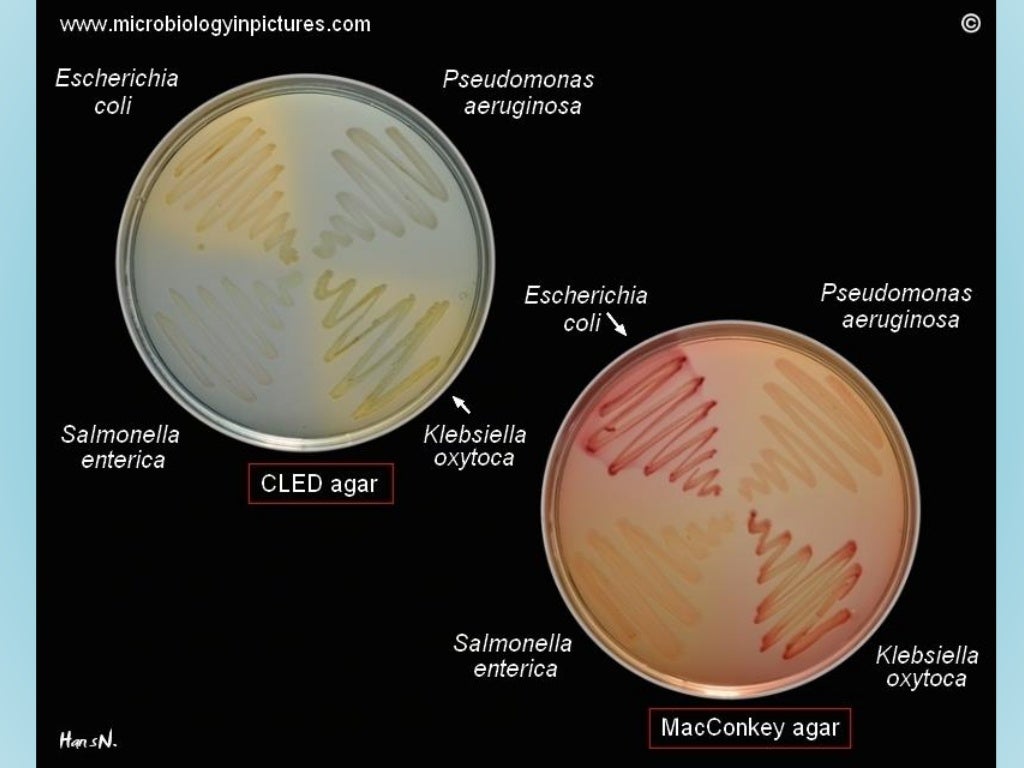

1. Meios Não Seletivos: Permitem o crescimento de uma ampla variedade de microrganismos, facilitando a observação geral. No entanto, podem não ser ideais para isolar espécies específicas. 2. Meios Seletivos: São úteis quando se busca isolar um grupo específico, mas podem falhar se houver variação nas características de resistência.. b) Meio enriquecido: Neste meio, além das fontes nutricionais usuais, são adicionados: sangue, soro, ovo, extrato de levedura, extratos teciduais, etc. Este meio de cultura permite o crescimento de microrganismos exigentes que necessitam de fatores de crescimento, porém não há inibição do crescimento de outros microrganismos. Ex.: ágar.
Microbiologia meios de cultura e provas de identificação

Microbiology Lab, Medical Laboratory Scientist, Scanning Electron Micrograph, Nursing School

O que é Meio de Cultura Saiba Mais

Uma Colonia De Bacterias Isolada Para Cultura Se Reproduz EDUCA

¿Qué es un coprocultivo? Mejor con Salud
Cientistas desenvolvem tecnologia para detectar bactérias em minutos Jornal O Globo

Bacteriologia Humana

O que é um Ágar Qual sua importância para os Meios de Cultura?
Microbiologia meios de cultura e provas de identificação

Cultivo de bacterias Laboratorios González

Cultura de las bacterias imagen de archivo. Imagen de cultura 98247167
Microbiologia meios de cultura e provas de identificação

CULTURA PARA IDENTIFICAÇÃO DE BACTÉRIAS YouTube

Cultura de las bacterias foto de archivo. Imagen de colonia 70355334

Cultura Bacteriana Colônias de Bactérias Microbiologia InfoEscola

Cultura Bacteriana Das Colônias Em Meios Diferenciais E Seletivos Imagem de Stock Imagem de

Prácticas de Microbiología. Pruebas bioquímicas para la identificación de bacterias. Vídeo 8
Uma Colonia De Bacterias Isolada Para Cultura Se Reproduz EDUCA

Culturing the Unculturable Bacteria Promega Connections

Cultura de las bacterias imagen de archivo. Imagen de médico 79117389
O Agar Cled é o meio de cultura indicado para contagem microbiana total de bactérias presentes na urina e para diferenciação de bactérias fermentadoras e não fermentadoras de lactose. É recomendado para bacteriologia urinária, auxiliando o crescimento de todos os patógenos urinários para boa diferenciação de colônias e.. Cultura é o crescimento microbiano em um meio nutricional sólido ou líquido; um número maior de microrganismos simplifica a identificação. A cultura facilita também a suscetibilidade antimicrobiana. A comunicação com o laboratório é essencial. Embora a maioria das amostras seja inserida em meios inespecíficos (p. ex., ágar sangue.